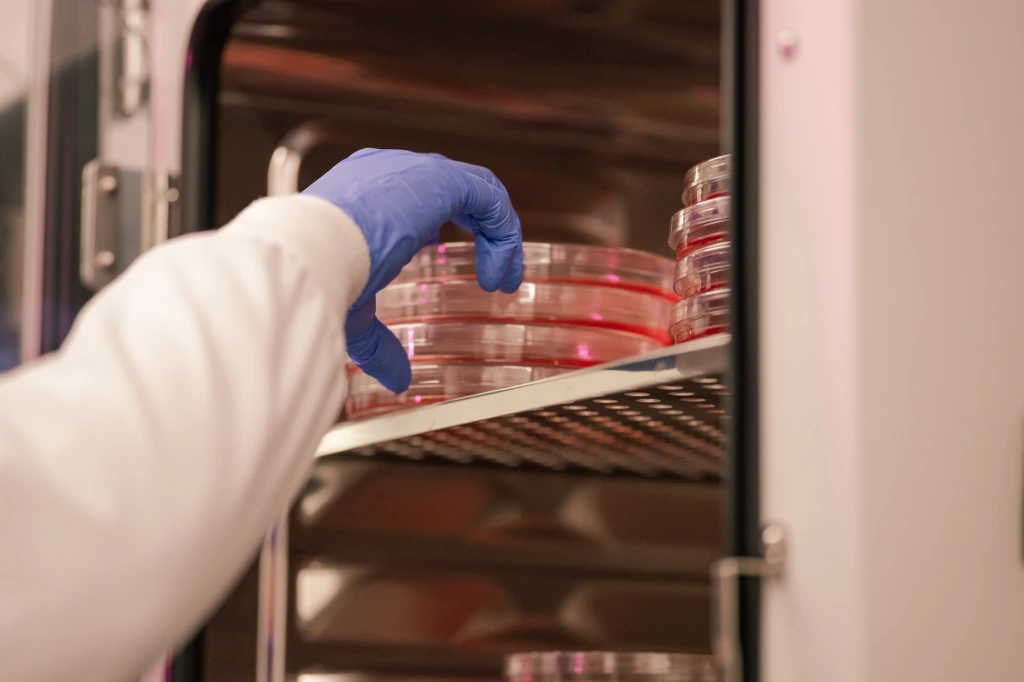
Gloved hand placing stacked petri dishes with red medium inside an incubator.

Anti-CD24: A Next Generation Cancer Immunotherapy
PHST001, our lead therapeutic candidate, is an anti-CD24 macrophage checkpoint inhibitor designed to overcome immune suppression in the tumor microenvironment. CD24, an immune receptor which was discovered by several Pheast co-founders, acts as a “don’t eat me” signal for cancer cells, shielding them from immune attack. By potently blocking the CD24-Siglec10 interaction, PHST001 enables macrophages to phagocytose cancer cells, initiating a powerful immune response.
Pheast has initiated a Phase 1 clinical trial of PHST001 in patients with advanced solid tumors (ClinicalTrials.gov Identifier: NCT06840886). The study will evaluate safety, pharmacokinetics, and early signs of anti-tumor activity, with the goal of establishing a recommended Phase 2 dose.
Phase 1 Clinical Trial
We are actively advancing our Phase 1 clinical trial and welcome inquiries from investigators, partners, and other interested parties. For more information about the study, please contact us.